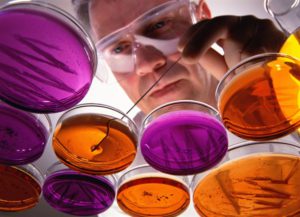
Микроскопический метод исследования

Сухая кожа стопы доставляет массу неудобств. Помимо косметических проявлений: шелушение, трещины, покраснение, поверхность стопы зудит и чешется. Причина такому явлению – грибок (микоз). Современная фармакология успешно справляется с лечением микоза. Препарат Тридерм снимает воспаление, подавляя бактерии, вызвавшие грибок стопы.

Активные элементы мази
Лечение грибковых заболеваний базируется на комплексном подходе. Мало устранить факторы, способствующие развитию инфекции, необходимо предотвратить дальнейшее ее распространение и исключить рецидив. Благодаря активным элементам, сосредоточенным в мази Тридерм, она оказывает противогрибковое, противовоспалительное и антибактериальное действие. В составе препарата такие вещества, как:
- Бетаметазон дипропионат (против воспаления).
- Клотримазол (подавляет грибок).
- Гентамицина сульфат (антибактериальное средство).
Комбинация трех составляющих подавляет симптомы заболевания. Антибиотик убивает бактерии, клотримазол разрушает мембрану грибков. Синтетический гормон бетаметазон борется с воспалением и аллергическими реакциями.
Показания к применению
 Мазь или крем Тридерм эффективен при лечении раздражения кожных покровов практически любого происхождения. Назначается дерматологом при комплексном медикаментозном лечении таких заболеваний кожи, как:
Мазь или крем Тридерм эффективен при лечении раздражения кожных покровов практически любого происхождения. Назначается дерматологом при комплексном медикаментозном лечении таких заболеваний кожи, как:
- атопический или аллергический дерматит;
- отрубевидный лишай;
- микоз, вызванный разного рода грибками;
- экзема;
- дерматиты после длительного лечения антибиотиками.
Важно: грибок стопы на начальной стадии медицинский препарат Тридерм излечивает в максимально короткий период. Улучшение заметно уже после первого нанесения мази на проблемный участок. Кожные покровы регенерируются, оставляя в прошлом зуд и шелушение.
Существуют противопоказания к применению. Это любая форма туберкулеза, высыпания венерического происхождения, открытые раны. В период беременности или кормления грудью, а также детям в возрасте до двух лет использование мази или крема Тридерм не рекомендовано.
Как использовать против грибка
Первые признаки заболевания стопы сигнализируют о немедленном обращении в медицинское учреждение. Микроскопический метод исследования поможет установить точный диагноз и выбрать правильное лечение.
Первые признаки заболевания стопы сигнализируют о немедленном обращении в медицинское учреждение. Микроскопический метод исследования поможет установить точный диагноз и выбрать правильное лечение.
Перед нанесением средства стопы необходимо распарить в теплой воде с добавлением соды. Высушив ноги полотенцем, нанести тонким слоем мазь или крем Тридерм и оставить до полного впитывания. Процедуру проводить ежедневно, два раза в сутки. Если в течение месяца нет видимого эффекта от применения препарата, надо обратиться к врачу для пересмотра методов лечения.
Бесконтрольное применение препарата может повлечь нежелательные аллергические реакции – зуд, раздражение, чувство жжения, гиперемию.
Важно: соблюдать рекомендации врача, использовать лекарственное средство согласно инструкции, не заниматься самолечением.
Warning: A non-numeric value encountered in /var/www/potlivost.ru/data/www/potlivost.ru/wp-includes/media.php on line 457
Warning: A non-numeric value encountered in /var/www/potlivost.ru/data/www/potlivost.ru/wp-includes/media.php on line 467
 Как лечить грибок ногтей у детей
Как лечить грибок ногтей у детей
Warning: A non-numeric value encountered in /var/www/potlivost.ru/data/www/potlivost.ru/wp-includes/media.php on line 457
Warning: A non-numeric value encountered in /var/www/potlivost.ru/data/www/potlivost.ru/wp-includes/media.php on line 467
 Как лечить грибок ногтей при беременности?
Как лечить грибок ногтей при беременности?
Warning: A non-numeric value encountered in /var/www/potlivost.ru/data/www/potlivost.ru/wp-includes/media.php on line 457
Warning: A non-numeric value encountered in /var/www/potlivost.ru/data/www/potlivost.ru/wp-includes/media.php on line 467
 Что такое грибок стопы
Что такое грибок стопы

